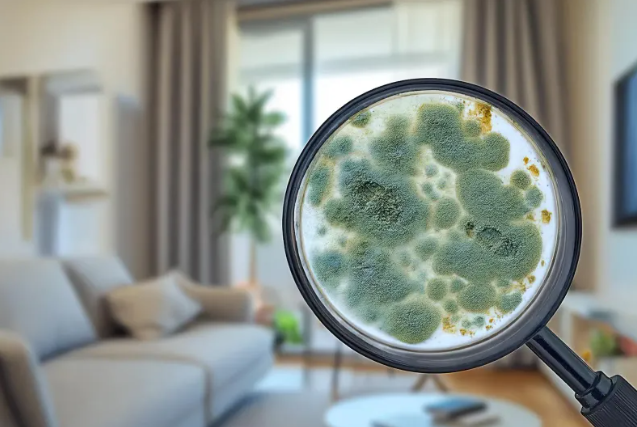

무더운 여름, 시원한 바람이 반가운 LG에어컨! 그런데 전원을 켜자마자 나는 꿉꿉하고 퀴퀴한 냄새, 경험 있으신가요?
이 글에서는 LG에어컨 냄새제거를 위한 셀프 필터 청소 방법과 필터 교체 타이밍, 그리고 믿고 맡길 수 있는 에어컨 청소 전문업체 선정 팁까지 전부 알려드리겠습니다.

목차
1. 에어컨에서 냄새가 나는 이유는?
에어컨 냄새의 대부분은 내부 곰팡이와 세균 번식이 원인입니다. 특히 필터와 열교환기(코일) 부위는 여름철 고온다습한 환경에서 세균이 쉽게 번식할 수 있어요. 에어컨 청소는 가족 건강 지키는 일입니다. 냄새의 원인을 정확히 아는 것이 곧 해결의 첫걸음입니다. 필터 속 곰팡이와 세균 지금 없애세요.

2. 셀프로 할 수 있는 LG에어컨 냄새제거 방법
① 필터 세척 방법
- 전원 OFF 후 에어컨 전면 커버를 열어 필터 분리
- 중성세제를 푼 미지근한 물에 담근 후 부드러운 솔로 세척
- 통풍이 잘 되는 그늘에서 완전 건조 후 재장착
② 냉각핀 청소
- 전용 에어컨 클리너(스프레이형) 사용
- 코일 부위에 분사 후 자연 건조
- 이때, 제품 라벨에 '코일 클리너' 문구가 있는지 확인하세요!
③ 에어컨 가동 전 환기 필수
- 세척 후 10~15분간 송풍 모드로 환기
- 습기 제거 및 곰팡이 냄새 예방에 탁월


3. 필터 교체는 언제 해야 할까?
LG 공식 가이드를 기준으로, 1~2년에 한 번은 필터 교체를 권장합니다.
만약 세척을 자주 했는데도 냄새가 나거나, 필터 색이 변색됐다면 교체를 고려해야 합니다.
🔧 LG전자 공식 홈페이지나 LG 서비스센터에서 정품 필터 구매 가능
4. 셀프 청소보다 전문가가 필요한 경우
- 냄새가 심하고 필터 청소 후에도 지속될 때
- 벽걸이 에어컨 내부까지 오염된 경우
- 스탠드형 또는 시스템 에어컨처럼 구조가 복잡할 때
이럴 땐 에어컨 청소 전문 업체를 찾는 것이 현명합니다. 여름이 다가오기 전 지금 부르세요! 곰팡이 퍼지기 전에 청소 필수입니다.


- 에어컨 청소 업체 고르는 꿀팁
✔ 후기 확인: 블로그, SNS에 사진 포함된 후기
✔ 가격 비교: 평균 청소비용(벽걸이 기준 6~9만 원)
✔ 방문 전 상담: 오염 상태 확인 후 정확한 견적 안내 여부
✔ LG에어컨 전문 가능 여부 확인
특히 ‘LG에어컨 전문 세척’, ‘코일 완전 분해’ 문구가 있는 업체는 신뢰도 높습니다.


에어컨은 여름 한 철만 사용하는 가전이 아니라 가족 건강과 직결되는 공기 관리 가전입니다.
정기적인 셀프 관리와 적절한 시점의 전문 청소로 쾌적한 여름을 준비해 보세요!
삼성전자 에어컨 사전점검 무료 신청, 무더운 여름대비
삼성전자는 여름철을 대비해 에어컨 사전점검 서비스를 무료로 제공하고 있습니다. 이 서비스는 소비자가 무더운 날씨 전에 미리 에어컨을 점검하여 고장이나 이상 여부를 확인하고, 보다 효율
hanul0410.com
여름 맞이 삼성 시스템에어컨 필터 셀프 청소부터 청소업체 선택까지
무더운 여름이 다가오면 가장 먼저 준비해야 할 것은 시원한 실내 환경입니다. 그 중심에 있는 삼성 시스템에어컨은 정기적인 관리와 청소가 필수입니다. 이번 글에서는 셀프로 가능한 필터 청
hanul0410.com